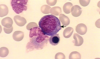
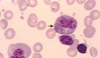

Hematopoiesis & Bone Marrow HistoTime Flashcards

Metamyelocyte
Identify the cell at the tip of the arrow. Identify the large cell immediately below this cell.

Blast cell; promyelocyte

Bone marrow

Polychromatophilic erythroblast
Identify the cell at the tip of the arrow. Identify the cell immediately adjacent to this cell.

Myelocyte; promyelocyte
What tissue fills most of the screen. Identify the structure that the arrow is in.

Bone marrow; sinusoidal capillary

Orthochromatophilic erythroblast

Band cell
Identify the cell at the tip of the arrow. Identify the large cell immediately below this cell.

Promyelocyte; Band cell

Blast cell
Identify the structure at the tip of the arrow. What kind of cells are these?

Endosteum (pulled away from bone above); Osteoblasts
Basophilic erythroblast

Megakaryocyte

Polychromatophilic erythroblast
Identify the material indicated by the arrow.

Bone marrow

Promyelocyte

Basophilic erythroblast

Band cell
Identify the cell at the tip of the arrow. Identify the two cells immediately above this cell.

Myelocyte; Polychromatophilic erythroblasts

Blast cell

Blast cell

Promyelocyte

Sinusoidal capillary in marrow cavity

Orthochromatophilic erythroblast
Metamyelocyte

Basophilic erythroblast

Myelocyte

Blast cell

Polychromatophilic erythroblast
Identify the material that fills the monitor screen. What is the cell at the tip of the arrow? What are the large round open areas due to?

Bone marrow; Megakaryocyte; Fat cells

Band cell

Blast cell

Orthochromatophilic erythroblast